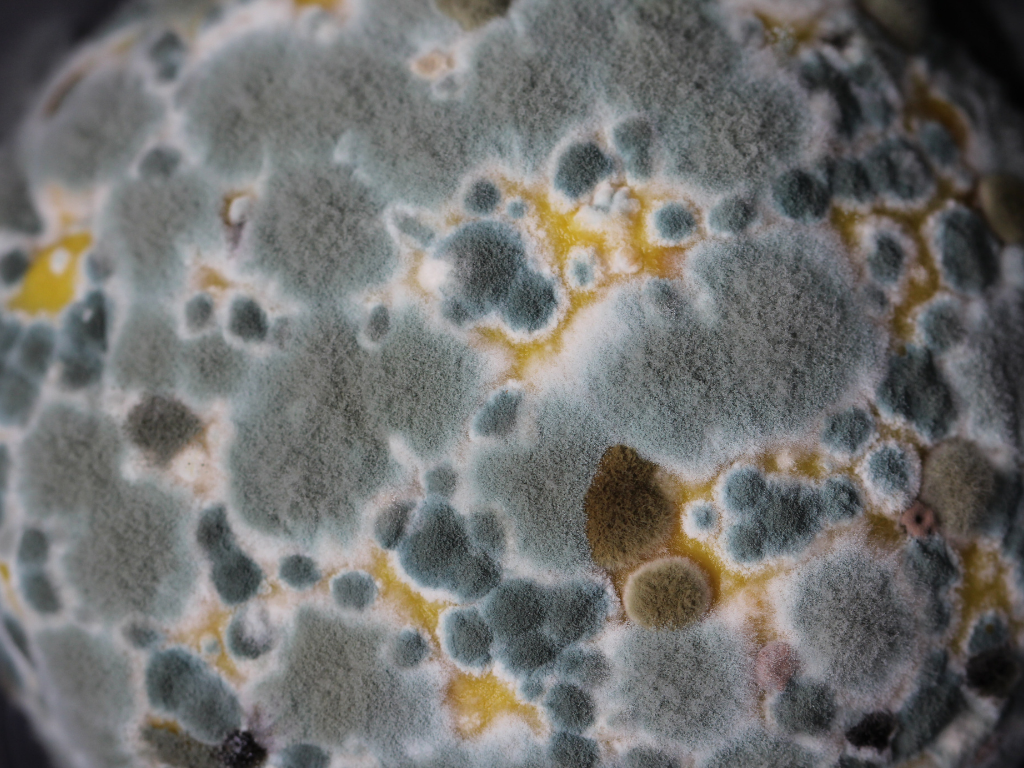
Cosmesi Naturale. Creme WaterLess e creme ad Emulsione: le Differenze

La dermatite e come combatterla
Macchie Bianche e Dermatite atopica : Ecco la Guida Completa
Continua a leggeresu Macchie Bianche e Dermatite atopica : Ecco la Guida Completa
Creme idratanti per la dermatite atopica dei bambini: verità scelte e consigli
Continua a leggeresu Creme idratanti per la dermatite atopica dei bambini: verità scelte e consigli
Cosa posso fare per le Macchie Bianche sulla Pelle? Consigli Utili in caso di Dermatite Atopica
Dermatite atopica: Quanta crema idratante devo mettere?
Continua a leggeresu Dermatite atopica: Quanta crema idratante devo mettere?
L'importanza dei laboratori cosmetici Biologici & Artigianali
I laboratori delle aziende cosmetiche sono sempre di più commerciali e orientati al business.
Continua a leggeresu L'importanza dei laboratori cosmetici Biologici & Artigianali
Creme WaterLess, il futuro della cosmesi
Tutte le aziende di cosmetica parlano di creme WaterLess e le descrivono come il futuro, ma nessuna azienda le produce!
A parte noi...
Continua a leggeresu Creme WaterLess, il futuro della cosmesi
Cosmesi Naturale. Creme WaterLess e creme ad Emulsione: le Differenze
Continua a leggeresu Cosmesi Naturale. Creme WaterLess e creme ad Emulsione: le Differenze
Gli effetti nocivi dei Siliconi chimici nei cosmetici
Continua a leggeresu Gli effetti nocivi dei Siliconi chimici nei cosmetici
Come riconoscere i Cosmetici Davvero 100% Naturali
Continua a leggeresu Come riconoscere i Cosmetici Davvero 100% Naturali
Dermatite atopica: il rischio nascosto di lavare il tuo bambino ogni giorno
Secondo la famosa e tanto studiata IPOTESI IGIENICA dell Dott. David P. Strachan nel 1989 "Vivere in un ambiente troppo curato dal punto di vista igienico, può facilitare l’insorgenza di allergie e problemi alla pelle." Scopri come prevenire irritazioni e problemi cutanei con la giusta detersione.
Continua a leggeresu Dermatite atopica: il rischio nascosto di lavare il tuo bambino ogni giorno
Dermatite Atopica: come lo stress danneggia la pelle
Continua a leggeresu Dermatite Atopica: come lo stress danneggia la pelle
Sconfiggi la dermatite atopica: scopri i segreti per una pelle sana e senza prurito!
Dermatite Atopica e alimentazione
Tensioattivi! Tutto quello che devi sapere...
Continua a leggeresu Tensioattivi! Tutto quello che devi sapere...
Irritazione e prurito: sapone liquido o solido? Ecco i 5 motivi della mia scelta
Ecco i 5 motivi per cui ho scelto...
Come attenuare prurito, infiammazione e secchezza della pelle del tuo bambino
Continua a leggeresu Come attenuare prurito, infiammazione e secchezza della pelle del tuo bambino
Dermatite Atopica nei Bambini: Il Legame Segreto con le Allergie e le Intolleranze Alimentari
Farmaci, influenza e dermatite : il ruolo degli integratori
Continua a leggeresu Farmaci, influenza e dermatite : il ruolo degli integratori
Allergie Primaverili e Dermatite Atopica nei Bambini: Soluzioni e Consigli
Continua a leggeresu Allergie Primaverili e Dermatite Atopica nei Bambini: Soluzioni e Consigli
Dolci di Pasqua Senza Rischi: Guida per Bambini con Irritazioni e Prurito
Continua a leggeresu Dolci di Pasqua Senza Rischi: Guida per Bambini con Irritazioni e Prurito
Come alleviare il prurito nella dermatite : 3 consigli pratici mai sentiti per il tuo bambino
Dermatite atopica e alimentazione: Ecco 3 alimenti da evitare quando c'è infiammazione
Come Prevenire le Ricadute della Dermatite Atopica: i Consigli di Metodo Pelle Sana
I Misteri della Dermatite Atopica nei Bambini: Fattori Scatenanti e Consigli Utili
Come Evito irritazioni in Piscina: Consigli Pratici
Continua a leggeresu Come Evito irritazioni in Piscina: Consigli Pratici
Gestione del Sudore nei Bambini Durante l'Estate: Consigli e Soluzioni
Continua a leggeresu Gestione del Sudore nei Bambini Durante l'Estate: Consigli e Soluzioni
Come Gestisco l'Irritazione da Sudore nel mio bambino. Consigli di Esperti
Continua a leggeresu Come Gestisco l'Irritazione da Sudore nel mio bambino. Consigli di Esperti
Mare e Irritazioni: 5 cosa che porto con me in spiaggia
Continua a leggeresu Mare e Irritazioni: 5 cosa che porto con me in spiaggia